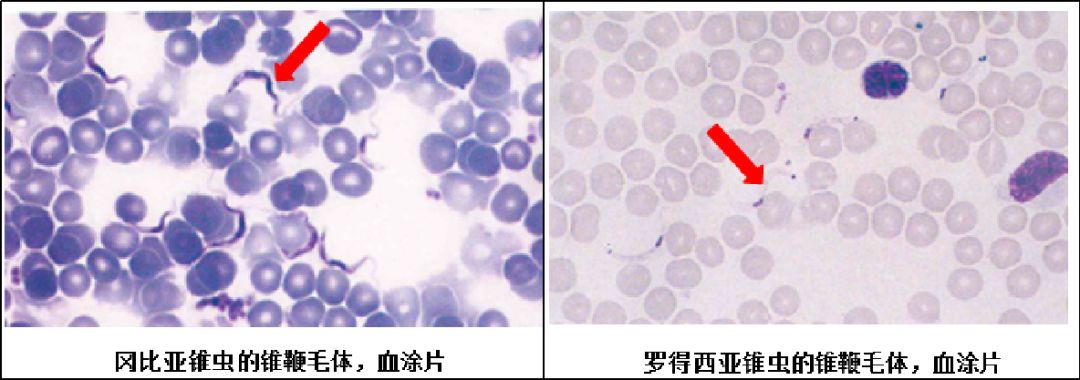
寻虫环游记第七站锥虫上非洲锥虫病

非洲锥虫

非洲锥虫病
图片尺寸318x265
锥虫
图片尺寸684x443
非洲昏睡病锥虫病
图片尺寸1200x800
这是克鲁斯锥虫吗?
图片尺寸309x339
p>锥虫属是 a href="#" data-lemmaid="2749689">原生动物门 /a>
图片尺寸400x265
感染后昏睡不醒!锥虫威胁非洲人健康
图片尺寸579x382
锥虫照片
图片尺寸612x467
虫——锥虫(trypanosoma)这种寄生虫大多分布在南美亚马逊雨林和非洲
图片尺寸700x466
罗得西亚锥虫同属于人体涎源性锥虫,是非洲锥虫病或称睡眠病的病原体
图片尺寸300x218
被锥蝽咬了是怎么样的8元1只得锥蝽没那么容易抓
图片尺寸500x334
福州黄女士在非洲旅游感染上锥虫病输入性罗得西亚锥虫病
图片尺寸582x368
寻虫环游记第七站锥虫上非洲锥虫病
图片尺寸1080x380
探秘虫子大家族一锥蝽
图片尺寸1040x653
是传染锥虫病的虫吗?
图片尺寸600x1067
虫谱大观锥蝽的身世
图片尺寸1080x720
三锥象科
图片尺寸1000x724
请问这种叫什么虫子?
图片尺寸400x400
虫谱大观锥蝽的身世
图片尺寸755x567
锥蝽分布的地区,锥虫病会经途径传播,出入过美洲地区的人员均可能会被
图片尺寸560x346
【虫谱大观】"锥蝽"的身世
图片尺寸474x316